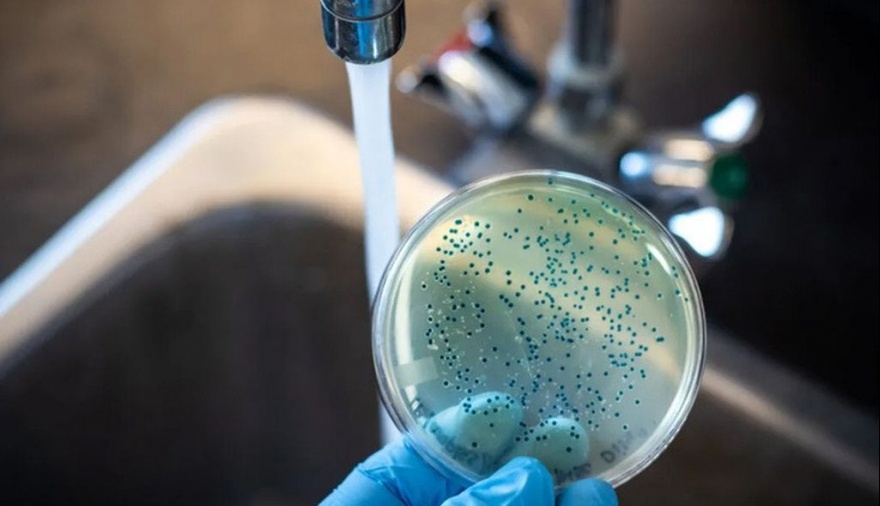

ATR
preocupacion
Qué es la Fiebre tifoidea, la enfermedad infecciosa que se detectó en Tres de Febrero con 17 casos confirmados
El brote alcanzó a dos edificios linderos y una mujer murió tras quedar internada. Cuáles son los síntomas, su prevención y tratamiento.
Las alarmas de Tres de Febrero se encendieron esta semana tras la detección de un brote de fiebre tifoidea que ya afectó a 17 personas de dos edificios ubicados en la localidad de Ciudadela donde unas 70 familias comparten un sistema de agua que no cuenta con control sanitario.
El Instituto Malbrán, confirmó la presencia de la bacteria Salmonella Typhi en muestras extraídas a los pacientes. Los afectados tienen entre 6 y 53 años, y al menos seis de ellos debieron ser hospitalizados. Una mujer falleció tras haber estado internada aunque aún no se confirmó oficialmente si el deceso fue consecuencia directa de la fiebre tifoidea.
Qué es la fiebre tifoidea
Es una enfermedad infecciosa causada por la bacteria Salmonella enterica serotipo Typhi (S. Typhi), que se transmite principalmente a través del consumo de agua o alimentos contaminados con heces humanas.
Los síntomas suelen aparecer entre 6 y 30 días después de la exposición a la bacteria e incluyen fiebre alta prolongada, dolor de cabeza, debilidad, dolor abdominal, estreñimiento o diarrea, y en algunos casos, erupciones cutáneas.
El diagnóstico se confirma mediante cultivos de sangre, heces, orina o médula ósea para detectar la presencia de S. Typhi.
El tratamiento principal consiste en la administración de antibióticos, como fluoroquinolonas, cefalosporinas o macrólidos, dependiendo de la resistencia bacteriana en la región.
Sin tratamiento adecuado, la fiebre tifoidea puede causar complicaciones graves, como perforación intestinal o septicemia, y puede ser mortal en aproximadamente el 10% de los casos.
La prevención se basa en medidas de higiene, como el lavado de manos, el consumo de agua potable y alimentos bien cocidos. Existen vacunas contra la fiebre tifoidea, recomendadas especialmente para personas que viajan a zonas endémicas.















